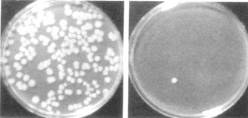
圖片1.png

紡織品抗菌性能測試方法分類
2018-11-21 13:48:19
天緯化學(xué)
紡織品抗菌性能的測試分為定量測試方法和定性測試方法,以定量測試方法最為重要��。
1 定量測試方法
目前紡織品抗菌性能定量測試方法及標(biāo)準(zhǔn)包括美國AATCC Test Method lO0(菌數(shù)測定法)TZ/TO2021-9�����、奎因(Quinn)實(shí)驗(yàn)法等��。
定量測試方法包括織物的消毒��、接種測試菌���、菌培養(yǎng)、對(duì)殘留的菌落計(jì)數(shù)等�����。它適用于非溶出性抗菌整理織物��,不適用于溶出性抗菌整理織物�,該法的優(yōu)點(diǎn)是定量、準(zhǔn)確���、客觀���,缺點(diǎn)是時(shí)間長�、費(fèi)用高�����。圖1是菌數(shù)測定法測試結(jié)果的例子��。
2 定性測試方法
定性測試方法主要有美國AATCC Test Method 9O(Halo Test��,暈圈法����,也叫瓊脂平皿法)、AATCC Test Method 124(平行劃線法)和JISZ2911-1981(抗微生物性實(shí)驗(yàn)法)等��。
|
圖l菌數(shù)測定法測試結(jié)果示意 |
定性測試方法包括在織物上接種測試菌和用肉眼觀察織物上微生物生長情況�。它是基于離開纖維進(jìn)入培養(yǎng)皿的抗菌劑活性,一般適于溶出性抗菌整理�����,但不適用于耐洗滌的抗菌整理����。優(yōu)點(diǎn)是費(fèi)用低���,速度快,缺點(diǎn)是不能定量測定抗菌活性�,結(jié)果不準(zhǔn)確。圖2是暈圈法測試結(jié)果的例子�。

|
圖2 暈圈法測試結(jié)果示意 |
我公司推出3Q系列殺菌劑、防腐劑�����、 殺菌劑����,環(huán)保無甲醛��,主要應(yīng)用在石油化工�、電力冶金等工業(yè)循環(huán)水處理,造紙工業(yè)�,木材工業(yè),涂料工業(yè)�����、皮革行業(yè)�、日化行業(yè)及金屬切削液等行業(yè)的殺菌��,防腐��,防霉����。